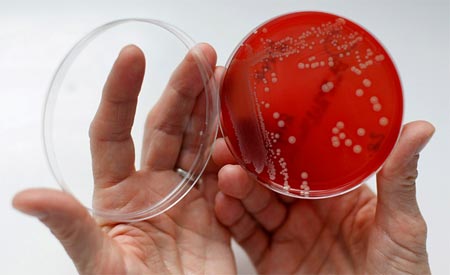

Кольпитом называют воспаление слизистой оболочки влагалища. В медицинской практике такое заболевание принято называть вагинитом. Это довольно распространенное болезненное состояние, которое наблюдается преимущественно у женщин репродуктивного возраста. Согласно статистике, каждая представительница слабого пола страдает различными формами кольпита, даже не подозревая об этом.
Возможные причины
Причиной развития такого заболевания, как кольпит, является инфекция. При этом здоровая слизистая влагалища способна справиться с инфекционной агрессией самостоятельно. Но как только иммунная система женщины дает сбой, полезная микрофлора переходит в разряд патогенной.
Симптомы
Признаки кольпита во многом определяются его формой и происхождением, однако они не отличаются большим разнообразием.
- Раздражение, покраснение и отечность в области наружных половых органов.
- Неприятный запах из влагалища (не резкий, но кислый).
- Болевые ощущения, которые локализуются в малом тазу. Следует отметить, что такой симптом кольпита может усиливаться в процессе интимной близости или во время акта дефекации.
- Чувство жжения и зуда, нарастающие во время длительной ходьбы, а также во второй половине дня или в период ночного отдыха.
- Регулярные позывы к мочеиспусканию, а иногда и недержание мочи.
- Бессонница, неврозы, повышенная раздражительность, которые вызываются целым комплексом симптомов болезни, постоянно беспокоящих женщину.
- Субфебрильные значения температуры тела.
Чем лечить?
Вагинальные свечи от кольпита используют чаще, нежели другие формы лекарственных средств.
Суппозитории активно применяются в лечебной практике, особенно в урологии, гинекологии и проктологии. Такая форма препарата имеет массу преимуществ перед, например, инъекциями или таблетками. К ним можно отнести следующие:
- Слизистая влагалища обладает достаточно развитой сетью кровеносных сосудов. В связи с этим скорость поступления лекарственных веществ в кровоток схожа с внутримышечной инъекцией.
- Органолептические свойства суппозиториев не имеют никакого значения, так как их не надо пробовать на вкус.
- Устанавливая свечи от кольпита, можно совершенно не беспокоиться о каких-либо осложнениях при введении, так как это совершенно безболезненная лечебная процедура.
- Используя суппозитории, можно добиться максимально возможной концентрации медикамента во влагалище. Это повысит эффективность терапии, а также поможет избежать возникновения устойчивости к лекарству.
- Растворяясь во влагалище и воздействуя на слизистую, свечи от кольпита, не создают нагрузку на такой орган, как печень.
- В отличие от других лекарственных форм, суппозитории гораздо меньше вызывают различные побочные эффекты, так как они практически не трансформируются в организме человека. Таким образом, терапевтический эффект достигается без причинения вреда больному и не нагружая его внутренние органы.
Несмотря на все преимущества, не всегда достаточно использовать лишь одни свечи от кольпита. Например, хронические формы воспаления и многие специфические заболевания требуют применения противомикробных и антибактериальных лекарств в форме таблеток или инъекций.
Какие свечи от кольпита лучше?
Чаще всего при воспалении слизистой влагалища врачи назначают своим пациентам комплексные суппозитории, включающие в себя несколько активных веществ. К ним относятся противомикробные, противогрибковые и антибактериальные компоненты, а также гормоны. Такой комплекс веществ, содержащийся в свечах от кольпита, может достаточно быстро снять основные симптомы упомянутого заболевания, в том числе зуд, болевые ощущения, жжение и пр.
Средняя продолжительность терапии такими препаратами составляет 7-14 дней. При этом следует отметить, что в большинстве случаев пациенту достаточно использовать лишь по одной свече на ночь, что более чем удобно.
О том, какие свечи от кольпита лучшие, расскажем далее.
Такой медикамент относится к группе комбинированных противогрибковых, противомикробных и антисептических средств, которые активно применяются в гинекологической практике.
Согласно инструкции по применению, такой препарат необходимо вводить глубоко во влагалище (по одной суппозитории, раз в день) на протяжении десяти суток.
Прежде чем ввести медикамент, его рекомендуется предварительно опустить в воду на 30 секунд или подержать в ладони около 2 минут.
Если суппозитория вводится днем, то после ее установки пациенту следует полежать не менее 10 минут.
Что касается третьего противобактериального ингредиента (нистатина), то он отличается фунгицидным действием в отношении грибковых штаммов рода Candida.
В инструкции по применению препарата сказано, что такие свечи следует использовать только местно, то есть интравагинально. Лучшим способом введения суппозитории является положение пациентки – лежа на спине. В сутки показано использование одной свечи, предпочтительно в вечернее время.
Курс лечения кольпита таким средством обычно занимает 12 дней.
Какие свечи от кольпита лучше? Специалисты утверждают, что эффективней всего с таким заболеванием борются препараты, которые содержат в себе несколько активных компонентов.
Такое действующее вещество, как нифурател, представляет собой производное нитрофурана. Он проявляет хорошую терапевтическую активность в отношении бактерий, грибов и трихомонад. Что касается нистатина, то он относится к антибиотическим средствам полиеновой группы. Такое вещество воздействует прямо на клетки возбудителя, нарушая их проницаемость и провоцируя гибель.
Такие эффективные свечи от кольпита используют интравагинально, по 1 суппозиторию, перед сном. Длительность курса лечения составляет 8 дней, однако при необходимости продолжительность терапии можно увеличить/уменьшить, но только по назначению специалиста.
Такое комбинированное интравагинальное средство содержит в себе два активных компонента:
- Метронидазол – представляет собой противомикробное и противопротозойное вещество, производное нитро-5-имидазола. К нему устойчивы факультативные анаэробы и аэробные микроорганизмы, однако в присутствии смешанной флоры оно действует синергически с антибиотическими лекарствами, эффективными против аэробов.
- Миконазол – этот компонент способен оказывать противогрибковое действие в отношении дрожжевых грибов и дерматофитов. При интравагинальном введении рассматриваемое вещество подавляет биологический синтез эргостерина в грибах, а также изменяет состав липидных составляющих в их мембране, что способствует гибели грибковых клеток.
Изучая список свечей от кольпита, следует понимать, что каждый из представленных препаратов имеет свои фармакологические особенности, побочные эффекты и противопоказания к применению. Поэтому использовать их следует только по назначению врача.
Рассматриваемый препарат относится к группе имидазолов и проявляет антипротозойные и противомикробные свойства против огромного спектра анаэробных бактерий.
Входящий в состав лекарства дексаметазон является кортикостероидом (синтетическим) и обладает противовоспалительным и иммуносупрессивным действием. Также этот компонент устраняет зуд, влияет на энергетический метаболизм, снижает интенсивность воспаления.
Хлорамфеникол – это противомикробное лекарственное вещество, которое особенно активно против грамположительных и грамотрицательных микроорганизмов. Оно нарушает синтез белка в микробных клетках, оказывая бактериостатическое действие.
Что касается нистатина, то этот компонент представляет собой противогрибковый антибиотик. После его проникновения в клетки микроорганизмов, он связывается с эргостеролами, вызывая дальнейшую гибель бактерий.
Рассматриваемые свечи от кольпита при беременности использовать нельзя. То же касается грудного вскармливания. Применяются суппозитории интравагинально, один раз в день (по одной свече), перед сном.
Период лечения таким препаратом может занять 10-12 дней. В этот период желательно избегать половых контактов.
Активными веществами указанных препаратов являются миконазол и метронидазол. Чаще всего такие средства назначают при неспецифическом кольпите.
Миконазола нитрат – это противогрибковое вещество, производное имидазола. Оно проявляет выраженную активность в отношении большинства грибов рода Candida и некоторых грамположительных бактерий.
Что касается метронидазола, то это противопротозойное средство.
Активным компонентом такого препарата является орнидазол (является аналогом метронидазола). Также в качестве основных веществ в состав свечей входят: нистатин, преднизолон и неомицин.
Такие суппозитории очень часто используются для терапии трихомонадного кольпита, неспецифического воспаления слизистой влагалища и молочницы.
Лечение атрофического кольпита
В большинстве случаев свечи от кольпита, названия которых были перечислены выше, используют для терапии всех видов заболевания, кроме атрофического. Чтобы вылечить последний, в состав суппозиторий должен входить эстрогенный компонент. К таким наиболее эффективным и популярным средствам относят:
Недорогие суппозитории
Все комплексные свечи от кольпита, отзывы о которых носят весьма неоднозначный характер, имеют высокую цену. Для значительного снижения стоимости лечения некоторые пациенты используют препараты с одним активным веществом. К самым популярным и действенным можно отнести следующие:
Препараты для восстановления биоценоза
После основного лечения кольпита рекомендуется пройти курс, необходимый для восстановления микрофлоры влагалища. Для этого специалисты рекомендуют использовать следующие средства:
Суппозитории для стимуляции иммунитета
Во время терапии некоторых видов кольпитов пациентам нередко назначают лекарства, усиливающие собственный иммунитет. К таким препаратам относят:
Отзывы об эффективности вагинальных свечей
Согласно утверждениям специалистов, вагинальные свечи при кольпите помогают справиться с болезнью максимально эффективно и быстро. Это связано с тем, что суппозитории обладают целым рядом преимуществ перед другими лекарственными формами. Что касается пациентов, то большинство из них согласно с мнением врачей. Они считают, что вагинальные свечи способны довольно быстро устранить все имеющие симптомы заболевания. Хотя бывают и такие случаи, когда такие препараты не способствуют улучшению состояния, а иногда пациенты и вовсе начинают жаловаться на его ухудшение. Специалисты объясняют это наличием у препаратов побочных явлений. Поэтому использовать подобные средства следует только после полного обследования и консультации с доктором.
27.01.2018 лечение 15,032 Просмотры
Что такое кольпит
Кольпит – широко распространенное заболевание воспалительного характера, поражающее слизистую оболочку влагалища. По-другому болезнь называют вагинитом.
Чаще всего патология развивается у женщин детородного возраста. Хотя проблема, в основном, диагностируется у взрослых, болезнь возможна и у детей до 10 лет и ранее. Пик заболеваемости среди детей приходится на шестилетний возраст. Иногда такой диагноз ставят даже пожилым пациенткам или взрослым женщинам климактерического периода.
Примечание! Тяжесть течения кольпита зависит от причин, вызвавших воспалительный процесс и от возраста.
Возбудители заболевания
Воспаление слизистой влагалища может произойти в результате проникновения чужеродной микрофлоры, в состав которой входят различные патогенные микроорганизмы. Если инфекция занесена извне, говорят о специфическом виде кольпита. Возбудителями патологии в таком случае могут быть:
- микоплазма;
- гонококк;
- хламидия;
- грибы Кандида;
- трихомонады;
- вирусы.
О неспецифическом вагините говорят, когда условно-патогенная микрофлора попала в организм женщины не извне, а она сама была носителем инфекции. Патогенные микроорганизмы в незначительных количествах присутствуют во влагалище здоровой женщины, но при сочетании группы факторов, начинают активное размножение. Спровоцировать бактериальный кольпит могут такие возбудители:
- стрептококк;
- стафилококк;
- синегнойная палочка;
- кишечная палочка.
Некоторые надеются, что гинекологические проблемы пройдут самостоятельно, без применения адекватных методов лечения. Хотя случаи самоизлечения встречаются, это редкое явление. Такое возможно только при развитии неспецифических форм кольпита и при условии сильного иммунитета.
Стоит быть осторожной, если симптомы внезапно исчезли. Независимо от того, появился вагинит у девочек, или это кольпит после родов, исчезновение признаков болезни не говорит об излечении. Патология может перейти в скрытую вялотекущую форму, а в последствие, вызвать обострения.
Причины появления кольпита
Как уже упоминалось, основными причинами развития кольпита считается заселение микрофлоры влагалища патогенной микрофлорой. Именно на фоне этих факторов воспалительное заболевание развивается у женщин репродуктивного возраста. Чаще всего инфекция заносится именно половым путем. При этом совершенно необязательно, что женщина должна вести беспорядочный образ жизни.
Когда патологию определяют у ребенка, причиной обычно становятся инфекции, проникшие в половые пути из пищеварительного тракта. Возбудителями воспаления могут быть стафилококки, стрептококки или даже острицы. В большинстве случаев происходит самозаражение.
Вагинит при климаксе также преимущественно развивается из-за неполовых инфекций. Нередко кольпит сопровождается молочницей. Тяжелые формы болезни обычно развиваются при условии наличия сопутствующих заболеваний или патологически отягощающих факторов.
Факторы риска
Дать толчок развитию воспалительного процесса могут определенные факторы:
- отсутствие тщательной интимной гигиены;
- наличие половых инфекций;
- много половых партнеров;
- чрезмерное увлечение гигиеной, частые спринцевания;
- проблемы со щитовидной железой;
- ношение тесного синтетического белья;
- травмы половых органов;
- изменение гормонального фона, например, при беременности;
- период менопаузы;
- раковые заболевания;
- прохождение лучевой терапии;
- присутствие в организме ВИЧ-инфекции;
- длительное применение антибактериальных препаратов;
- употребление гормональных средств;
- наличие аллергии;
- нехватка витаминов;
- аборт или выкидыш в анамнезе;
- заболевания органов ЖКТ;
- применение внутриматочных контрацептивов;
- несбалансированное питание;
- тяжелые роды;
- дисфункция яичников;
- перенесенное выскабливание матки.
Независимо от факторов, спровоцировавших развитие кольпита, от него необходимо избавиться как можно скорее.
Классификация
Классификация кольпита включает несколько разновидностей заболевания и каждая имеет свои особенности. Ниже описаны те, что чаще всего встречаются в гинекологической практике:
- трихомонадный;
- кандидозный;
- атрофический.
Трихомонадный кольпит вызывается простейшими микроорганизмами – трихомонадами. Инфекция чаще всего передается половым путем. Реже заразиться можно, используя с больным человеком общие предметы обихода. При обнаружении патологии на ранней стадии вылечить болезнь просто. Чтобы поставить диагноз, врачу обычно достаточно просто осмотреть пациентку и выслушать жалобы.
Кандидозный кольпит возникает в результате активного размножения патогенных грибов рода Кандида. Его отличительные симптомы – творожистые выделения белого цвета и сильный зуд. Заразиться можно как от другого человека, так как просто на фоне снижения собственного иммунитета и изменения качественного состава микрофлоры.
Атрофический кольпит связан с изменением гормонального фона в организме женщины. Когда эстрогены не вырабатываются в нужном количестве, влагалище изменяется. Иногда эти явления связаны с возрастными изменениями. Появляются боли при половом акте, женщина чувствует сухость и дискомфорт. Лечение сенильного кольпита (старческого) проводится с использованием гормонов.
По характеру течения вагинита выделяют две формы:
- острую;
- хроническую.
Редко развивается аллергический вагинит. В таком случае заболевание имеет неинфекционную природу и развивается в результате контакта с аллергеном. Терапия проводится после определения раздражающего фактора и исключения контакта с ним.
Гнойные выделения появляются у женщин только при развитии неспецифической формы вагинита. При специфических кольпитах такие явления, как правило, не возникают.
Симптоматика заболевания
Чем раньше удастся распознать первые признаки заболевания, тем быстрее можно начать лечить женщину. Нельзя пренебрегать развитием таких симптомов:
- жжение в области влагалища;
- зуд;
- болезненность при половом акте;
- мелкие эрозии;
- обильные выделения, иногда гнойные или пенистые;
- неприятный запах;
- отек влагалища;
- гиперемия кожных покровов около вагины;
- раздражительность, вызванная постоянным зудом;
- бессонница;
- периодические болезненные ощущения в малом тазу;
- частые позывы к мочеиспусканию;
- субфебрилитет.
Важно! Даже инфекционные заболевания далеко не всегда могут выражаться повышением температуры, поэтому симптомами нельзя пренебрегать.
Вагинит может быть опасен, если его не долечить. Патология просто переходит в скрытую форму, но может повлечь неприятные осложнения, вплоть до бесплодия. Поэтому важно, чтобы врач убедился, что кольпит полностью излечен.
Диагностические мероприятия
Первое обследование, которое проводится гинекологом – осмотр женщины в специальном кресле с помощью зеркал. Врач увидит диффузное покраснение, отметит рыхлость тканей, отечность и точечные кровоизлияния. При запущенных формах болезни возможны небольшие эрозии. Некоторые из клинических признаков можно увидеть на фото.
Врач возьмет мазок на анализ, чтобы определить состав микрофлоры и наличие патогенных микроорганизмов. Затем он проведет пальпацию матки с целью определения ее положения, степени напряженности на предмет развития осложнений.
Помимо осмотра диагностика включает:
- проведение полимеразно цепной реакции;
- кольпоскопии;
- общий анализ крови и мочи;
- анализ крови на половые инфекции.
После получения всех данных доктор сможет оценить состояние пациентки и выдать рецепт с наиболее эффективными препаратами.
Лечение кольпита
При кольпите проводится лечение в домашних условиях. Применяются местные и общие методики. Любые лекарственные препараты, а также народные способы используются только после консультации с лечащим врачом.
Во время борьбы с вагинитом важно тщательно соблюдать следующие рекомендации:
- обеспечить полный половой покой, так как интимные отношения в этот период могут спровоцировать распространение инфекции и ее переход в соседние органы;
- при специфических формах патологии применяются антибактериальные лекарства;
- даже если симптоматика полностью исчезла, курс терапии важно завершить, так как инфекция может остаться и это вызовет хроническое течение кольпита;
- важно не использовать во время лечения синтетическое белье;
- терапию следует проводить одновременно обоим половым партнерам;
- необходимо следить за диетой;
- избегать переохлаждения;
- проводить туалет наружных половых органов не реже двух раз в день.
Примечание! Если вагинит развился у ребенка, подмывать девочку необходимо после каждого посещения туалета.
В зависимости от типа заболевания и выявленного возбудителя врач может рекомендовать проведение спринцеваний. Такие процедуры не следует проводить больше 4-5 дней, так как это может привести к нарушению нормальной микрофлоры влагалища и помешать процессам заживления. Растворы для проведения спринцеваний можно приготовить с использованием таких средств:
- марганцовка;
- отвар ромашки и шалфея;
- риванол;
- хлорофиллипт;
- сода.
Иногда спринцевания заменяют или дополняют сидячими ванночками.
Нередко врачи назначают противовоспалительные вагинальные свечи от кольпита. Комплексное лечение помогает скорее улучшить самочувствие и избавиться от симптомов заболевания. Рассмотрим препараты, которые рекомендуют пациенткам чаще всего.
Применяемое лечение может напрямую зависеть от типа возбудителя. Если вагинит был вызван гарднереллой, доктор назначит:
При заражении трихомонадой применяют:
Важно! Лечение трихомониаза проводится трехкратно в течение трех менструальных циклов.
При поражении грибами рода Кандида назначаются такие препараты:
При запущенных формах кольпита применяют не только местное, но и общее лечение. В зависимости от состояния пациентки лекарственные средства могут применяться в виде таблеток или даже инъекций.
Могут быть назначены такие медикаментозные средства:
После того, как патогенная микрофлора уничтожена, важно восстановить полезную флору. Для этих целей применяют следующие препараты:
Помимо этого рекомендуется принимать витаминные комплексы и препараты, стимулирующие защитные силы организма.
Лечение народными средствами включает спринцевание отварами и настоями. Эффективны такие составы:
- отвар ромашки;
- разведенный настой календулы;
- отвар смеси трав из листьев мать-и-мачехи, тимьяна, душицы, зверобоя и крапивы;
- отвар коры можжевельника;
- растворенный настой череды и листьев эвкалипта.
Благотворно на состояние микрофлоры влагалища действуют облепиховые свечи. Приобрести их можно в любой аптеке. Перед тем, как начать лечение, необходимо проконсультироваться с врачом. Это не заменяет основную медикаментозную терапию.
Профилактика
Профилактика кольпита включает в себя такие мероприятия:
- плановое посещение гинеколога каждые полгода;
- тщательное соблюдение интимной гигиены с применением деликатных дезинфицирующих средств;
- правильное использование туалетной бумаги во избежание занесения инфекции из прямой кишки;
- ношение нательного белья из натуральных тканей;
- отказ от самолечения и бесконтрольного применения гормональных средств и антибиотиков;
- ведение здорового образа жизни и укрепление иммунных сил.
Благодаря этим простым способам профилактики риск заболеть кольпитом будет сведен к минимуму.
Своевременное лечение кольпита позволит избежать неприятных последствий заболевания. Женщина, перенесшая такое состояние, успешно может выносить и родить здорового ребенка.
Смотрите видео:
https://youtube.com/watch?v=XGos5rAqJ5Q
Кольпит — воспаление во влагалище, которое может возникать как в результате инфекционного процесса, так и по причине аллергии, снижения иммунитета и т.д. Значимая роль в лечении подобных состояний отдается использованию свечей. Такое местное лечение имеет множество преимуществ перед системно действующими препаратами. Какие особенности выбора вагинальных свечей? Могут ли быть недорогие еще и эффективными?
Читайте в этой статье
Преимущества свечей перед другими формами лекарств
Свечи — производственная форма выпуска лекарственных препаратов, в домашних условиях их могут заменить тампоны с мазями, растворами, в том числе из народной медицины. Суппозитории широко используются в лечебной практике, особенно в гинекологии, урологии, проктологии. Они имеют массу преимуществ перед таблетками и инъекциями лекарств. К основным можно отнести:
- Слизистая влагалища имеет очень развитую сеть кровеносных сосудов. Поэтому скорость поступления лекарственного средства в кровоток сравнима с внутримышечной инъекцией.
- Закладывая суппозитории, можно не беспокоиться о каких-то осложнениях введения. Это безболезненная процедура.
- Не важны органолептические свойства свечей, так как их не придется пробовать на вкус.
- Используя свечи, можно создать максимально возможную концентрацию препарата именно во влагалище. Это поможет избежать развития устойчивости к лекарству и повысит эффективность лечения.
- Растворяясь и действуя на слизистой во влагалище, свечи не создают нагрузку на печень, так как нет необходимости в переработке лекарства до активной формы.
- На суппозитории достоверно меньше встречаются различные побочные реакции, так как они меньше подвергаются трансформации в организме.
Но не всегда для эффективного лечения достаточно использования только суппозиториев. Хронические формы воспаления во влагалище, а также многие специфические кольпиты требуют назначения антибактериальных и противомикробных препаратов в виде таблеток или инъекций.
А здесь подробнее о трихомонадном кольпите.
Особенности выбора вагинальных свечей при кольпите
Кольпит условно можно разделить на три вида: специфический, вследствие активации условно-патогенной флоры, а также атрофический. Для каждого существуют свои лечения, которые направлены на ликвидацию факторов, провоцирующих воспаление. Только учитывая особенности возникновения кольпита можно выбрать наиболее действенные схемы терапии. Для этого важно пройти полное обследование, которое и установит все нюансы течения заболевания у женщины.
Возникает при активации условно-патогенной флоры. В норме такие бактерии могут находиться в небольшом количестве в вагинальном секрете. При определенных условиях они начинают активно размножаться, вызывая тем самым дисбиоз и воспаление. Чаще всего это стрепто- и стафилококки, кишечная палочка, клебсиелла, дрожжевые грибы и некоторые другие.
После этого можно приступать к лечению. При этом часто достаточно использования только свечей местно. Основные принципы терапии неспецифического кольпита следующие:
- Свечи с противомикробным, антибактериальным, противовоспалительным действием. Это могут быть препараты на основе антисептиков (хлоргексидин, йод, Гексикон и т.п.). В некоторых случаях предпочтительнее сделать выбор в пользу суппозиториев с антибиотиками или комплексным действием. Все зависит от клинической картины и степени выраженности воспаления.
- Для последующего восстановления микрофлоры влагалища рекомендуется использовать свечи на основе молочнокислых бактерий. Спектр препаратов большой, выбор на усмотрение врача и женщины.
Специфический кольпит отличается тем, что он вызван определенным возбудителем. Это могут быть бактерии, вирусы, простейшие и т.п. Чаще всего приходится сталкиваться со следующими:
- хламидии,
- микоплазмы,
- уреаплазмы,
- трихомонады,
- гонококки,
- бледная трепонема (вызывает сифилис),
- вирусы папилломы человека и простого герпеса 1 и 2 типов и другие.
При специфическом кольпите свечи – дополнение к основному лечению. Для полной эрадикации инфекции необходимо использовать антибактериальные и противомикробные препараты системно (в виде инъекций, таблеток для внутреннего приема и т.д.). Если применять только свечи, можно уменьшить проявления воспаления, но избавиться полностью от недуга вряд ли получится. В подобных ситуациях высок риск перехода заболевания в хроническую форму и развития осложнений.
По окончанию курса основного лечения следует закрепить результат, используя свечи с молочнокислыми бактериями. Так можно предотвратить возникновение бактериального вагиноза, кандидоза и других форм нарушения флоры влагалища.
Синонимы атрофического кольпита – сенильный, старческий. Возникает у женщин в менопаузе или после удаления обоих яичников в любом возрасте. Основная причина для развития атрофического кольпита — недостаток эстрогенов, результатом чего является истончение слизистой влагалища и ее повышенная травматизация, резкое снижение количества палочек Дедерлейна, уменьшение слизи. Как итог — боль, дискомфорт, сухость в области наружных и внутренних половых органов.
Лечение атрофического кольпита только тогда будет эффективным, если к основной схеме добавлены гормоны в минимальной дозировке. Это могут быть как пероральные формы (например, Фемостон), так и суппозитории с добавлением эстрогенов.
Смотрите на видео о кольпите у женщин:
https://youtube.com/watch?v=XGos5rAqJ5Q
Какие свечи в гинекологии лучшие от кольпита
Часто предпочтение отдается комплексным свечам, которые включают в себя несколько действующих веществ. Как правило, это противогрибковый, противомикробный, антибактериальный компонент, а также гормон. Такой комбинацией можно быстро снять основные тревожащие симптомы кольпита (зуд, жжение, боль и другие).
Средняя продолжительность лечения свечами – 7 — 14 дней, при этом в большинстве случаев достаточно закладывать по одному суппозиторию на ночь.
К наиболее действенным и популярным можно отнести следующие:
| Препарат | Применение |
| Тержинан | Содержит 4 действующие вещества: тернидазол (от трихомонад и простейших) неомицин (противомикробное), нистатин (противогрибковое), преднизолон (гормон). Последний компонент оказывает дополнительное противовоспалительное действие, а также помогает быстро избавиться от жжения, зуда. Выпускается в виде вагинальных таблеток — удобная форма, аналог обычным свечам. Цена за 10 штук в пределах 500 рублей. |
| Полижинакс | Состоит из 3 действующих веществ: неомицин, полимиксин (противомикробое) и нистатин. По эффекту похож на Тержинан, но без гормонального компонента. За 12 свечей придется отдать около 600 — 700 рублей. |
| Макмирор комплекс | Содержит нистатин и нифурател. Последний активен по отношению ко многих бактериям, простейшим, в том числе к трихомонадам. За 8 свечей придется заплатить порядка 800 рублей. |
| Гинокапс | Выпускается в вагинальных капсулах и содержит миконазол 100 мг — противогрибковый компонент, а также метронидазол 100 мг. Сходный по составу препарат — Румизол. Но он содержит 500 мг метронидазола, это значительно более высока доза. Препарат активен по отношению к трихомонадам, многим условно-патогенным бактериям. Стоимость Гинокапса в пределах 500 рублей, Румизола — 600. |
| Микожинакс | Содержит 4 компонента: метронидазол (противомикробное и противопротозойное действие), нистатин (антибиотик с воздействием на грибы), хлорамфеникол (уничтожает многих условно-патогенных бактерий), дексаметазон — гормон. По своему эффекту он близок к Тержинану, но обеспечивает действие другими веществами. Поэтому Микожинакс может использоваться при возникновении резистентности к другим препаратам. |
| Нео-пенотран и Клион-Д | Содержат метронидазол и миконазол (противогрибковое средство). Назначают препарат чаще при неспецифическом кольпите. В Нео-пенотран Форте дополнительно входит лидокаин, который оказывает местное анестезирующее действие. Цена в пределах 800 — 1000 рублей за 14 свечей. |
| Мератин-комби | Содержит в составе орнидазол (аналог метронидазола), нистатин, неомицин и преднизолон. Используется для лечения трихомонадного кольпита, молочницы, а также неспецифического воспаления. Стоимость около 400 рублей за 10 вагинальных таблеток. |
Самостоятельно сложно выбрать подходящие свечи. Наиболее действенные и безопасные может подобрать только врач.
Для лечения атрофического кольпита в состав свечей вносится эстрогенный компонент. Из наиболее эффективных и популярных можно выделить следующие:
- Гинофлор Э, помимо эстриола содержит дополнительно лактобактерии. Это позволяет добиться максимальной эффективности за курс лечения. Но цена их в пределах 1000 рублей за 6 свечей. Обычно курс включает неделю-две, для профилактики следует раз в 6-12 месяцев пользоваться этими суппозиториями даже без жалоб.
- Овестин содержит эстриол. За 5 штук придется заплатить около 400 рублей. Полные аналоги лекарства — Эстриол, Эстровагин.
Какие недорогие свечи лучше применять от кольпита
Все комплексные свечи имеют достаточно высокую цену. Чтобы несколько снизить стоимость лечения, можно использовать препараты с одним действующим веществом. Из популярных и действенных можно выделить следующие:
| Препарат | Действие и стоимость |
| Гексикон | Свечи на основе хлоргексидина. Он обладает широким спектром действия по отношению к условно-патогенной и специфической флоре (трихомонадам, хламидиям и другим). Средняя цена за 14 свечей – около 300 рублей. |
| Бетадин | Свечи на основе йода. Данный микроэлемент относится к антисептическим и противомикробным средствам. Он безопасен и может использовать даже для лечения трихомонадного кольпита. Цена за 7 свечей – около 300 рублей. Аналоги стоят еще дешевле, например, Йодосепт — 150 рублей за 10 штук. |
| Трихопол | Вагинальные таблетки на основе метронидазола. Используются при вагинозах, гарднереллезе, вагинитах, в том числе трихомонадных. Цена за 10 штук – 200 — 325 рублей. |
| Нистатин | Противогрибковые свечи. Данное действующее вещество входит в состав многих комплексных препаратов. Стоимость его за 10 свечей — 70 рублей. |
| Клотримазол | Вагинальные таблетки с противогрибковой активностью. Цена 30 рублей за 10 штук. |
| Облепиховые свечи | Являются неплохой альтернативой суппозиториям с половыми гормонами для лечения атрофического кольпита. Это дешевый вариант — всего 70 рублей за 10 штук. |
Средства для восстановления биоценоза
- Лактожиналь — свечи с лактобактериями. Стоимость за 10 суппозиториев около 600 рублей.
- Бифидумбактерин содержит одноименные бактерии, адсорбированные на частичках угля. В виде свечей — 90 рублей за 10 штук.
- Вагинорм С — свечи на основе аскорбиновой кислоты. Стоимость 600 рублей за 10 суппозиториев.
Свечи для стимуляции иммунитета
При лечении некоторых кольпитов, особенно с вирусным поражением, в обязательную схему входят препараты для усиления собственного иммунитета в борьбе с инфекцией. Чаще всего используются следующие свечи с этой целью:
- Кипферон, включает несколько видов интерферонов. Цена около 600 рублей за 10 штук.
- Генферон содержит только альфа-интерферон. Стоимость 270 рублей за 10 свечей.
А здесь подробнее о творожистых выделениях перед месячными.
Свечи — надежный и эффективный метод лечения кольпитов. Суппозитории имеют много преимуществ перед другими формами лекарств и широко используются в гинекологии. Но воспаление во влагалище часто отражает процессы, происходящие во всем организме, поэтому использование только свечей может перевести болезнь в хроническую форму. Любая схема лечения должна быть согласована с врачом. Только специалист после обследования может назначить наиболее подходящую и действенную терапию.
Читайте также: